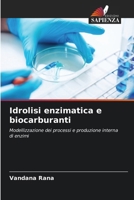
Idrolisi enzimatica e biocarburanti 6209622267 Book Cover
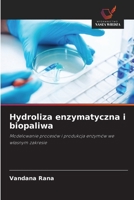
Hydroliza enzymatyczna i biopaliwa 6209632505 Book Cover

Renewable Biofuels: Bioconversion of Lignocellulosic Biomass by Microbial Community
$54.99

Enzymatic Hydrolysis and Biofuels
Out of Stock
Idrolisi enzimatica e biocarburanti
Out of Stock
Hydroliza enzymatyczna i biopaliwa
Out of Stock

Enzymatische Hydrolyse und Biokraftstoffe
Out of Stock

Hydrolyse enzymatique et biocarburants
Out of Stock